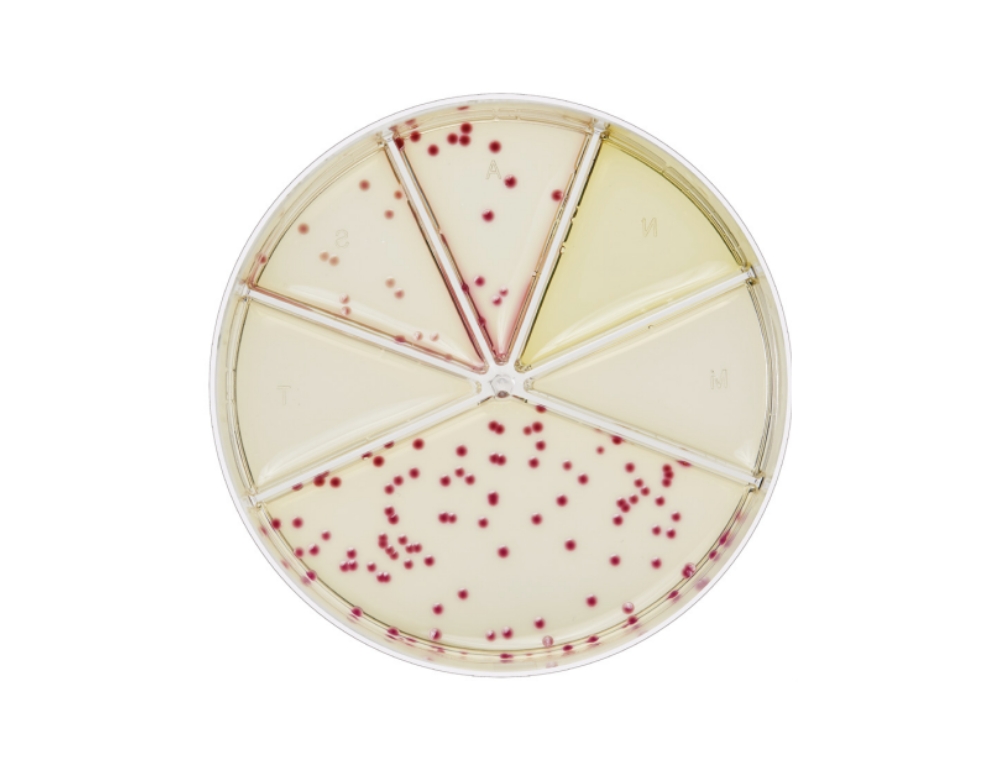
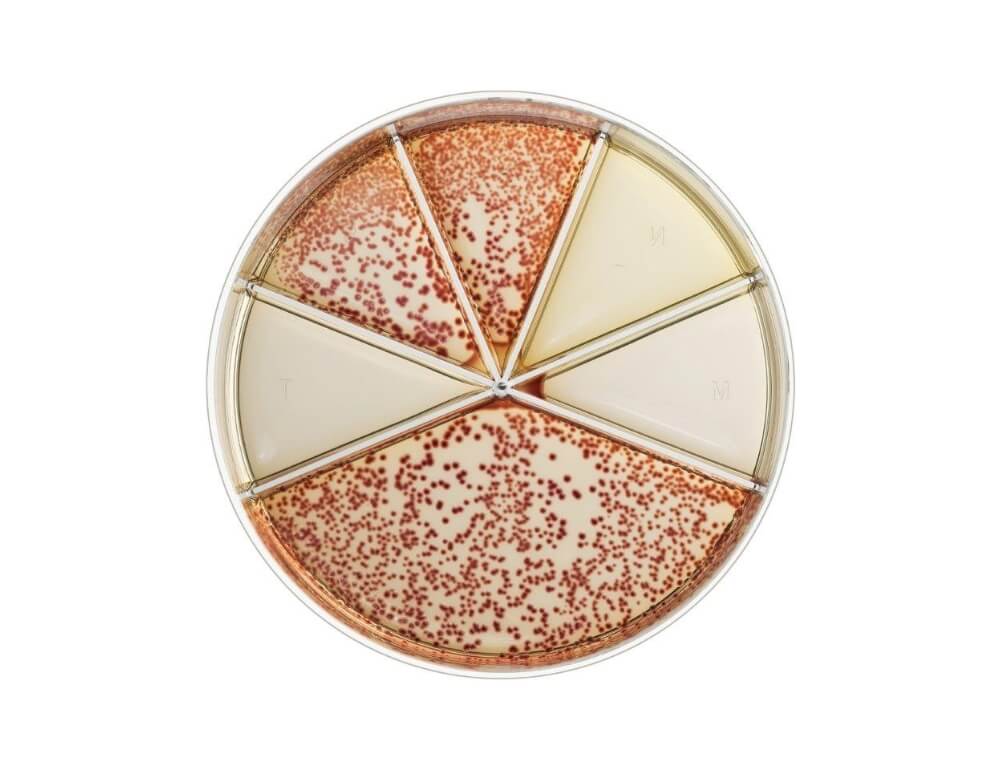

| Fragt | |||
| Total Moms |
|
||
| Total inkl. moms |
| Eksempel |
![]() ![]() |
| 103 cfu/ml |
| Eksempel |
![]() ![]() |
| 105 cfu/ml |
Patienten med mistænkt urinvejsinfektion (UVI) leverer en urinprøve.
Prøven mærkes med patientens navn og dato.
Urinprøven, der ønskes undersøgt, sås ud manuelt på Flexicult® Urinkit, ved at afsætte 6 dråber i det store rum, som er kontrolfeltet, og ved at afsætte 2 dråber i hvert af de 5 antibiotikafelter.
Pladen vippes, så prøvematerialet kommer i kontakt med hele agaroverfladen.
Flexicult® urinkitpladen inkuberes aerobt ved 35 °C (± 2 °C) med bunden opad i 16-24 timer. Efter endt inkubering aflæses kontrolfeltet for vækst og en kvantitering i CFU/mL foretages.
Da agaren indeholder en fastlagt mængde af de forskellige antibiotika, skal pladen aflæses med vækst/ikke vækst.
Efter inkubering natten over ved 35 °C, vil de enkelte bakterier være vokset frem til synlige kolonier. Bakterier vil vokse frem i de antibiotikumfelter, hvor de er resistente over for pågældende antibiotikum. Bakterier, der er følsomme, vil være hæmmet af antibiotikumkoncentrationen, og vil ikke vokse, dvs. blive til kolonier. Væksten sammenlignes med kontrolfeltet.

| 103cfu/ml | 105cfu/ml |
Kilde: ssidiagnostica.dk
Download SSIs produktbrochure for Flexicult® urinkit her
(inkl. vejledning til aflæsning af Flexicult® agarpladens farvefelt)
Flexicult® urinkittet er udformet som en agarplade med forhøjede sider, opdelt i felter med skillevægge og et tilhørende låg. Der er ét stort tællefelt til semikvantitativ bestemmelse og 5 mindre felter med hvert deres antibiotikum.
Antibiotikakoncentrationen af hvert stof er indstillet således, at relevante urinvejspatogener kan svares ud som enten følsomme (væksten hæmmes totalt eller signifikant) eller resistente (vækst som i kontrolfeltet).
Til mediet er desuden tilsat kromogener, der spaltes af bakteriernes enzymer, således at kolonierne fremtræder med forskellige farver på agaren.

Urinprøver for rigtig antibiotikabehandling fra begyndelsen
- mindre behov for bredspektrede antibiotika

Farveindikation og kvantificering til bakteriel identifikation

Nem fortolkning baseret på farveændring, størrelse og mængde af kolonier